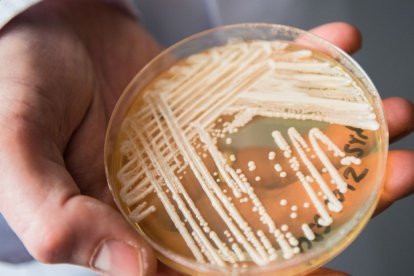
Científico sostiene una placa de Petri que contiene Candida auris.

¿Qué hongo causó la enfermedad del hincha de Millonarios que solicitó la eutanasia?
Javier Acosta, de 36 años, recibirá la eutanasia en el mediodía del 30 de agosto del 2024. Su desición la tomó debido a una mortal bacteria

Candida auris es la bacteria que afectó a Javier Acosta.
A las 12:00 p.m. (hora de Colombia) del 30 de agosto de 2024, Javier Acosta, un ferviente hincha de Millonarios FC, tomó la drástica decisión de poner fin a su vida. Esta decisión fue el resultado de una lucha desgarradora contra un hongo invasivo que fue deteriorando poco a poco su salud.
(Lea también: El drama de ecuatorianos deportados de Panamá: “Nos trataron como animales")
En diversas entrevistas, Acosta relató cómo este patógeno fue apagando su vida, llevándolo al límite y, finalmente, a optar por la eutanasia.
¿Cómo contrajo Javier Acosta su enfermedad?
Hace cinco años, este apasionado del fútbol colombiano sufrió un accidente en Tuluá que lo dejó en silla de ruedas. Su situación se agravó cuando, durante un viaje a Melgar, contrajo el hongo Candida auris en una piscina.
Aunque en su testimonio Javier se refirió a esta infección como una bacteria, en realidad se trata de un hongo. El Candida auris afectó inicialmente su glúteo izquierdo, para luego extenderse al glúteo derecho.
Los médicos, en un principio, sugirieron amputarle una pierna, pero al poco tiempo descubrieron que también padecía cáncer en la sangre.
Este caso ha generado preocupación en Colombia, ya que plantea preguntas sobre el riesgo que corren quienes disfrutan de piscinas y la posibilidad de contraer la misma infección que Javier.
Animalízate Fest: Un evento solidario a favor del bienestar animal
¿Qué es la Candida auris?
Según el portal web MedlinePlus.gov, Candida auris es un tipo de levadura que puede causar infecciones graves en pacientes hospitalizados o en residencias de ancianos, quienes suelen estar ya muy enfermos, como en el caso de Javier, quien había tenido un accidente previo.
Las infecciones por Candida auris generalmente no responden a los medicamentos antimicóticos tradicionales, lo que indica que el hongo es resistente a estos tratamientos. Esta resistencia complica enormemente el manejo de la infección.
En cuanto a su transmisión, el portal explica que algunas personas pueden portar Candida auris en su cuerpo sin enfermarse, un estado conocido como colonización. Sin embargo, estas personas aún pueden diseminar el hongo y están en riesgo de desarrollar una infección.
¿Quieres acceder a todo el contenido de calidad sin límites? ¡SUSCRÍBETE AQUÍ!
En cajas de banano iban 1.3 toneladas de droga que tenían destino fuera de Ecuador